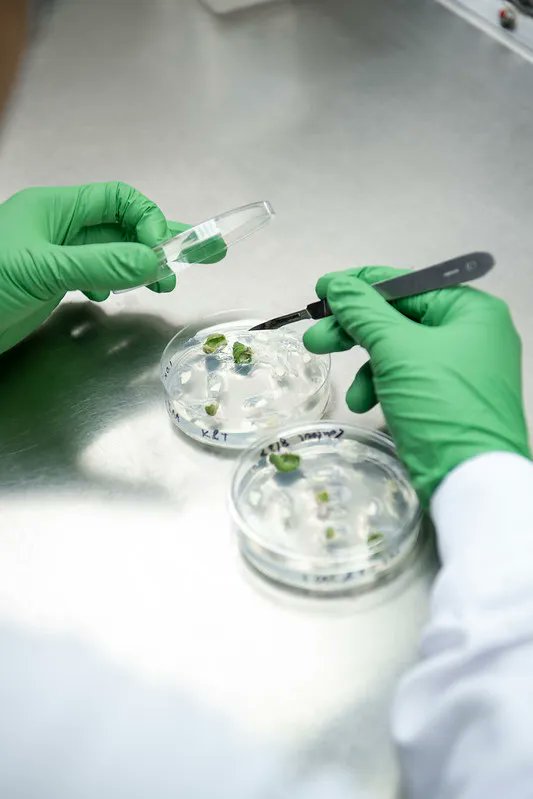
The Department of Crop Sciences is searching for an outstanding candidate for a Visiting Research Scientist position. We seek highly qualified applicants with a strong commitment to excellence. See the job posting here: 
buff.ly/3j1sgoq

Crop Sciences
@illinoiscropsci
The latest from the Department of Crop Sciences at #ILLINOIS. Start at Illinois. Then together we will feed and fuel world.
ID: 2923218753
http://www.cropsciences.illinois.edu 15-12-2014 17:26:07
762 Tweet
2,2K Followers
580 Following